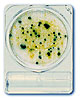

Análisis de Detección de Microorganismos

Compact Dry®
Compact Dry es un procedimiento sencillo y seguro para la determinación y cuantificación de microorganismos en productos alimenticios, cosméticos y otras materias primas, incluidas las farmacéuticas.
Formatos

Compact Dry EC
Compact Dry EC permite la detección y diferenciación entre coliformes y E. coli . El medio contiene dos sustratos enzimáticos cromógenos: Magenta-GAL y X-Gluc. De esta manera los coliformes desarrollan una coloración roja, mientras que la de los E. coli es azul.
Compact Dry CF
Compact Dry CF sirve para la detección rápida de coliformes: gracias al sustrato cromógeno X-Gal forman características colonias azules/verde-azuladas. El crecimiento de otros tipos de bacterias se inhibe considerablemente. Las bacterias que pudieran crecer aparecerían sin coloración alguna.

Compact Dry SA
Compact Dry SA es una placa cromogénica lista para usar para el recuento total de gérmenes Staphyloccous aureus.
Folleto Compact Dry SA.

Compact Dry YM
Compact Dry YM contiene sustratos cromogénos que permiten distinguir entre levaduras y hongos gracias a sus diferentes reacciones cromáticas y son por tanto sumamente fáciles de discriminar: el sustrato cromógeno X-Phos provoca una coloración azul en prácticamente todas las levaduras.
El crecimiento bacteriano se inhibe mediante antibióticos. Gracias a la cavidad de las placas Compact Dry, los mohos desarrollan su forma tridimensional característica en distintos colores

Compact Dry X-BC
Compact Dry X-BC es una placa cromogénica lista para usar para el recuento total de Bacillus cereus.

Compact Dry LS
Compact Dry LS es una placa cromogénica lista para usar para la detección de Listeria.
Folleto Compact Dry LS.

Compact Dry TC
Compact Dry TC es un medio para el recuento bacteriano total viable, que contiene agar estándar de nutrientes. Las colonias que crecen en Compact Dry TC son de color rojo debido a la sal de tetrazolio indicador redox. Datos de la línea de regresión de método Compact Dry TC representaron frente al método convencional PCA (agar de recuento en placa estándar) muestra una buena correlación por 100 muestras de alimentos para la población de microorganismos aerobios mesófilos.

Compact Dry AQ
Compact Dry AQ es una placa selectiva lista para ser usada para la detección y recuento de bacterias heterotróficas.
Compact Dry AQ.

Compact Dry PA
Compact Dry PA es una placa selectiva lista para ser usada para la detección de Pseudomonas aeruginosa. Se detectan porque las colonias aparecen de color rojo con un pigmento verdoso alrededor de la colonia.
Compact Dry PA.

Easy Plate®
Easy Plate son dispositivos de cultivo microbiológico compuesto por una lámina impermeable, un medio seco preparado sobre la lámina y una cubierta transparente sobre el medio.
Formatos

Easy Plate® AC
El método Easy Plate AC indica el nivel de bacterias aeróbicas en productos alimenticios como carne de res cruda, carne de cerdo, jamón, salchicha cocida, pollo crudo, lechuga, arándanos,camarones crudos, salmón crudo, atún crudo, leche pasteurizada, queso natural y alimento seco para mascotas. El método Easy Plate AC ha recibido Certificación AOAC Research Institute Performance Tested Methods SM (041302).

Easy Plate® CC
Easy Plate CC indica el nivel de bacterias coliformes en productos alimenticios. Enumeración de Escherichia coli y bacterias coliformes. El método Easy Plate CC ha recibido la certificación Performance Tested methods SM del Instituto de Investigación AOAC para carne de cerdo cruda molida, cordero crudo, pollo crudo molido, filete de atún crudo, filete de salmón crudo, camarones crudos, plátano fresco pelado, piña recién cortada y manzanas recién cortadas.

Easy Plate® EC
Easy Plate EC indica el nivel de Escherichia coli y bacterias coliformes en productos alimenticios seleccionados.

Easy Plate® SA
Easy Plate SA indica el nivel de Staphylococcus aureus en productos alimenticios.

Easy Plate YMR
Las Placa Compact Dry YMR están lista y fácil de usar. Las levaduras y los mohos se pueden diferenciar por el desarrollo del color. El medio contiene el sustrato enzimático cromogénico X-Phos, que se vuelve azul en muchas levaduras. Los mohos forman colonias esponjosas con un color característico. Compact Dry YM está aprobado por la AOAC.
